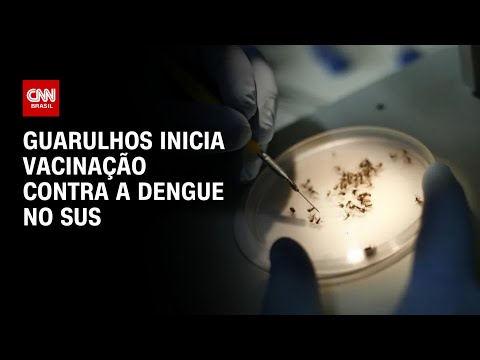

Vídeos
Guarulhos inicia vacinação contra a dengue no SUS | BASTIDORES CNN
Começou nesta terça-feira (20) a vacinação contra a dengue na cidade de Guarulhos, região metropolitana de São Paulo. Até o momento, o estado já registrou 15 óbitos pela doença desde o início deste ano. #CNNBrasil
Inscreva-se no canal da CNN Brasil no YouTube.
ACOMPANHE A CNN BRASIL TAMBÉM NAS OUTRAS PLATAFORMAS:
Podcasts: https://www.cnnbrasil.com.br/podcasts/
Newsletters: https://newsletter.cnnbrasil.com.br
Facebook: https://www.facebook.com/cnnbrasil
Twitter: https://www.twitter.com/cnnbrasil
Instagram: https://www.instagram.com/cnnbrasil
Fonte: CNN Brasil – Youtube



